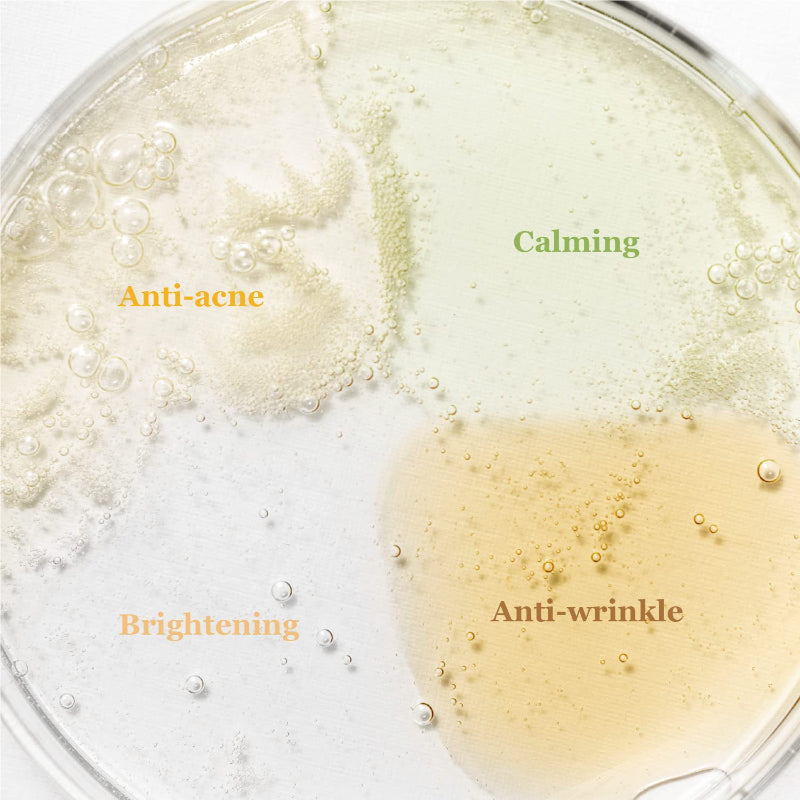
بيوتي اوف جوسون - مجموعة سيروم هانبانق الأستكشافية

بيوتي اوف جوسون - مجموعة سيروم هانبانق الأستكشافية
- 83.99 SR
94.42 SR- 83.99 SR
- سعر الوحدة
- ل
تعذر تحميل مدى توفر الطلب
تم إنشاء "مجموعة اكتشاف Hanbang" لأولئك الذين يرغبون في معرفة أي من السيروم من الأربعة الأفضل لبشرتهم.
هذه مجموعة صغيرة بحجم 10 مل تحتوي على 4 أنواع من السيروم بحيث يمكنك اختيار استخدامها أو طبقتها وفقًا لنوع بشرتك أو مشاكل البشرة. قم بتجربة رحلة رائعة للعثور على المنتج المناسب لك قبل أن تغوص في زجاجة كاملة الحجم!
الوصف لنوع جميع السيروم ؟
السيروم المهدئ بالشاي الأخضر + البانثينول
المكونات : ماء أوراق الشاي الأخضر 76% + بانثينول 2% + مستخلص كينتيللا اسياتيكا، مستخلص الأرتيميسيا الشائع، هيالورونات الصوديوم الملمس: نسيج مائي وخفيف الوزن
الفوائد: مهدئ
سيروم النضارة: بالعسل + نياسيناميد
المكونات : خلاصة العكبر 60% + نياسيناميد 2% + البيتين ساليسيلات (BHA)، زيت التامانو، مستخلص شجرة الشاي الملمس: ملمس يشبه العسل
الفوائد: مضاد لحب الشباب، مضاد للالتهاب
سيروم التوهج: بخلاصة الأرز + ألفا أربوتين
المكونات : ماء نخالة الأرز 68% + ألفا أربوتين 2% +الجلسرين، النياسيناميد، مستخلص بذور فول الصويا، مستخلص الشعير، مستخلص الأرز، مستخلص السمسم. الملمس: نسيج مائي وخفيف الوزن
الفوائد: مضاد للتصبغ، تفتيح
سيروم الاصلاح بالجينسنغ + موسين الحلزون
المكونات : ماء جذور الجينسنغ 63% + موسين الحلزون 3% + مستخلص جذور الجينسنغ، الأدينوزين، مستخلص ماتسوتاكي الملمس: خفيف الوزن، يشبه الميوسين
الفوائد: مضاد للتجاعيد، مضاد للتصبغ
وصف كيفية الاستخدام:
ضعي 2-3 قطرات من السيروم على البشرة ودلكي بلطف للمساعدة على الامتصاص .
صنع في كوريا
- يؤدي اختيار تحديد إلى تحديث كامل للصفحة.



